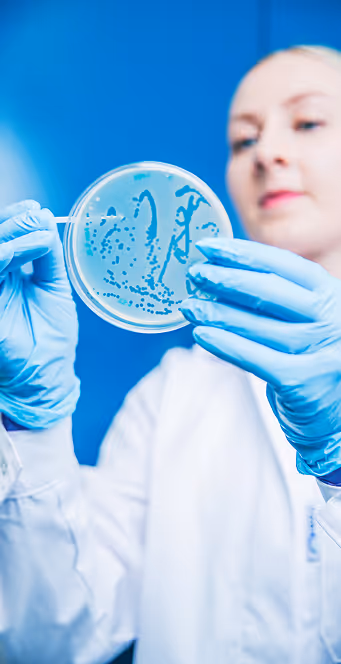
woman working with bacteriophages

Overcoming Key Challenges Faced by Phage Producers
As phage therapy and bacteriophage products move closer to clinical and commercial reality, producers face pressure to meet scientific and regulatory standards, scale production, and ensure genomic quality.
As phage therapy and bacteriophage products move closer to clinical and commercial reality, producers face pressure to meet scientific and regulatory standards, scale production, and ensure genomic quality.

We help you by providing
Easier Genomic Batch Quality Control
Phagenomics BatchQC software handles GMP-compliant genome integrity & contamination monitoring in an easy-to-use, scalable solution.
Phage isolation & characterisation
We isolate bacteriophages from natural reservoirs and tailor the process to your specific bacterial strains.

What Is It Like to Partner with PrecisionPhage
At PrecisionPhage, collaboration means combining goals with expertise to move projects forward with confidence. Whether you are exploring new phages, looking for bioinformatic solutions, or preparing for regulated applications, we provide science-driven, flexible support throughout projects.
At PrecisionPhage, collaboration means combining goals with expertise to move projects forward with confidence. Whether you are exploring new phages, looking for bioinformatic solutions, or preparing for regulated applications, we provide science-driven, flexible support throughout projects.

Customer testimonials
We are lucky to be trusted by top brands around the world.
Latest Phage News
Get in Touch
We’re here to help with any questions you may have. You can also find our team members and their contact details on the Team page.








